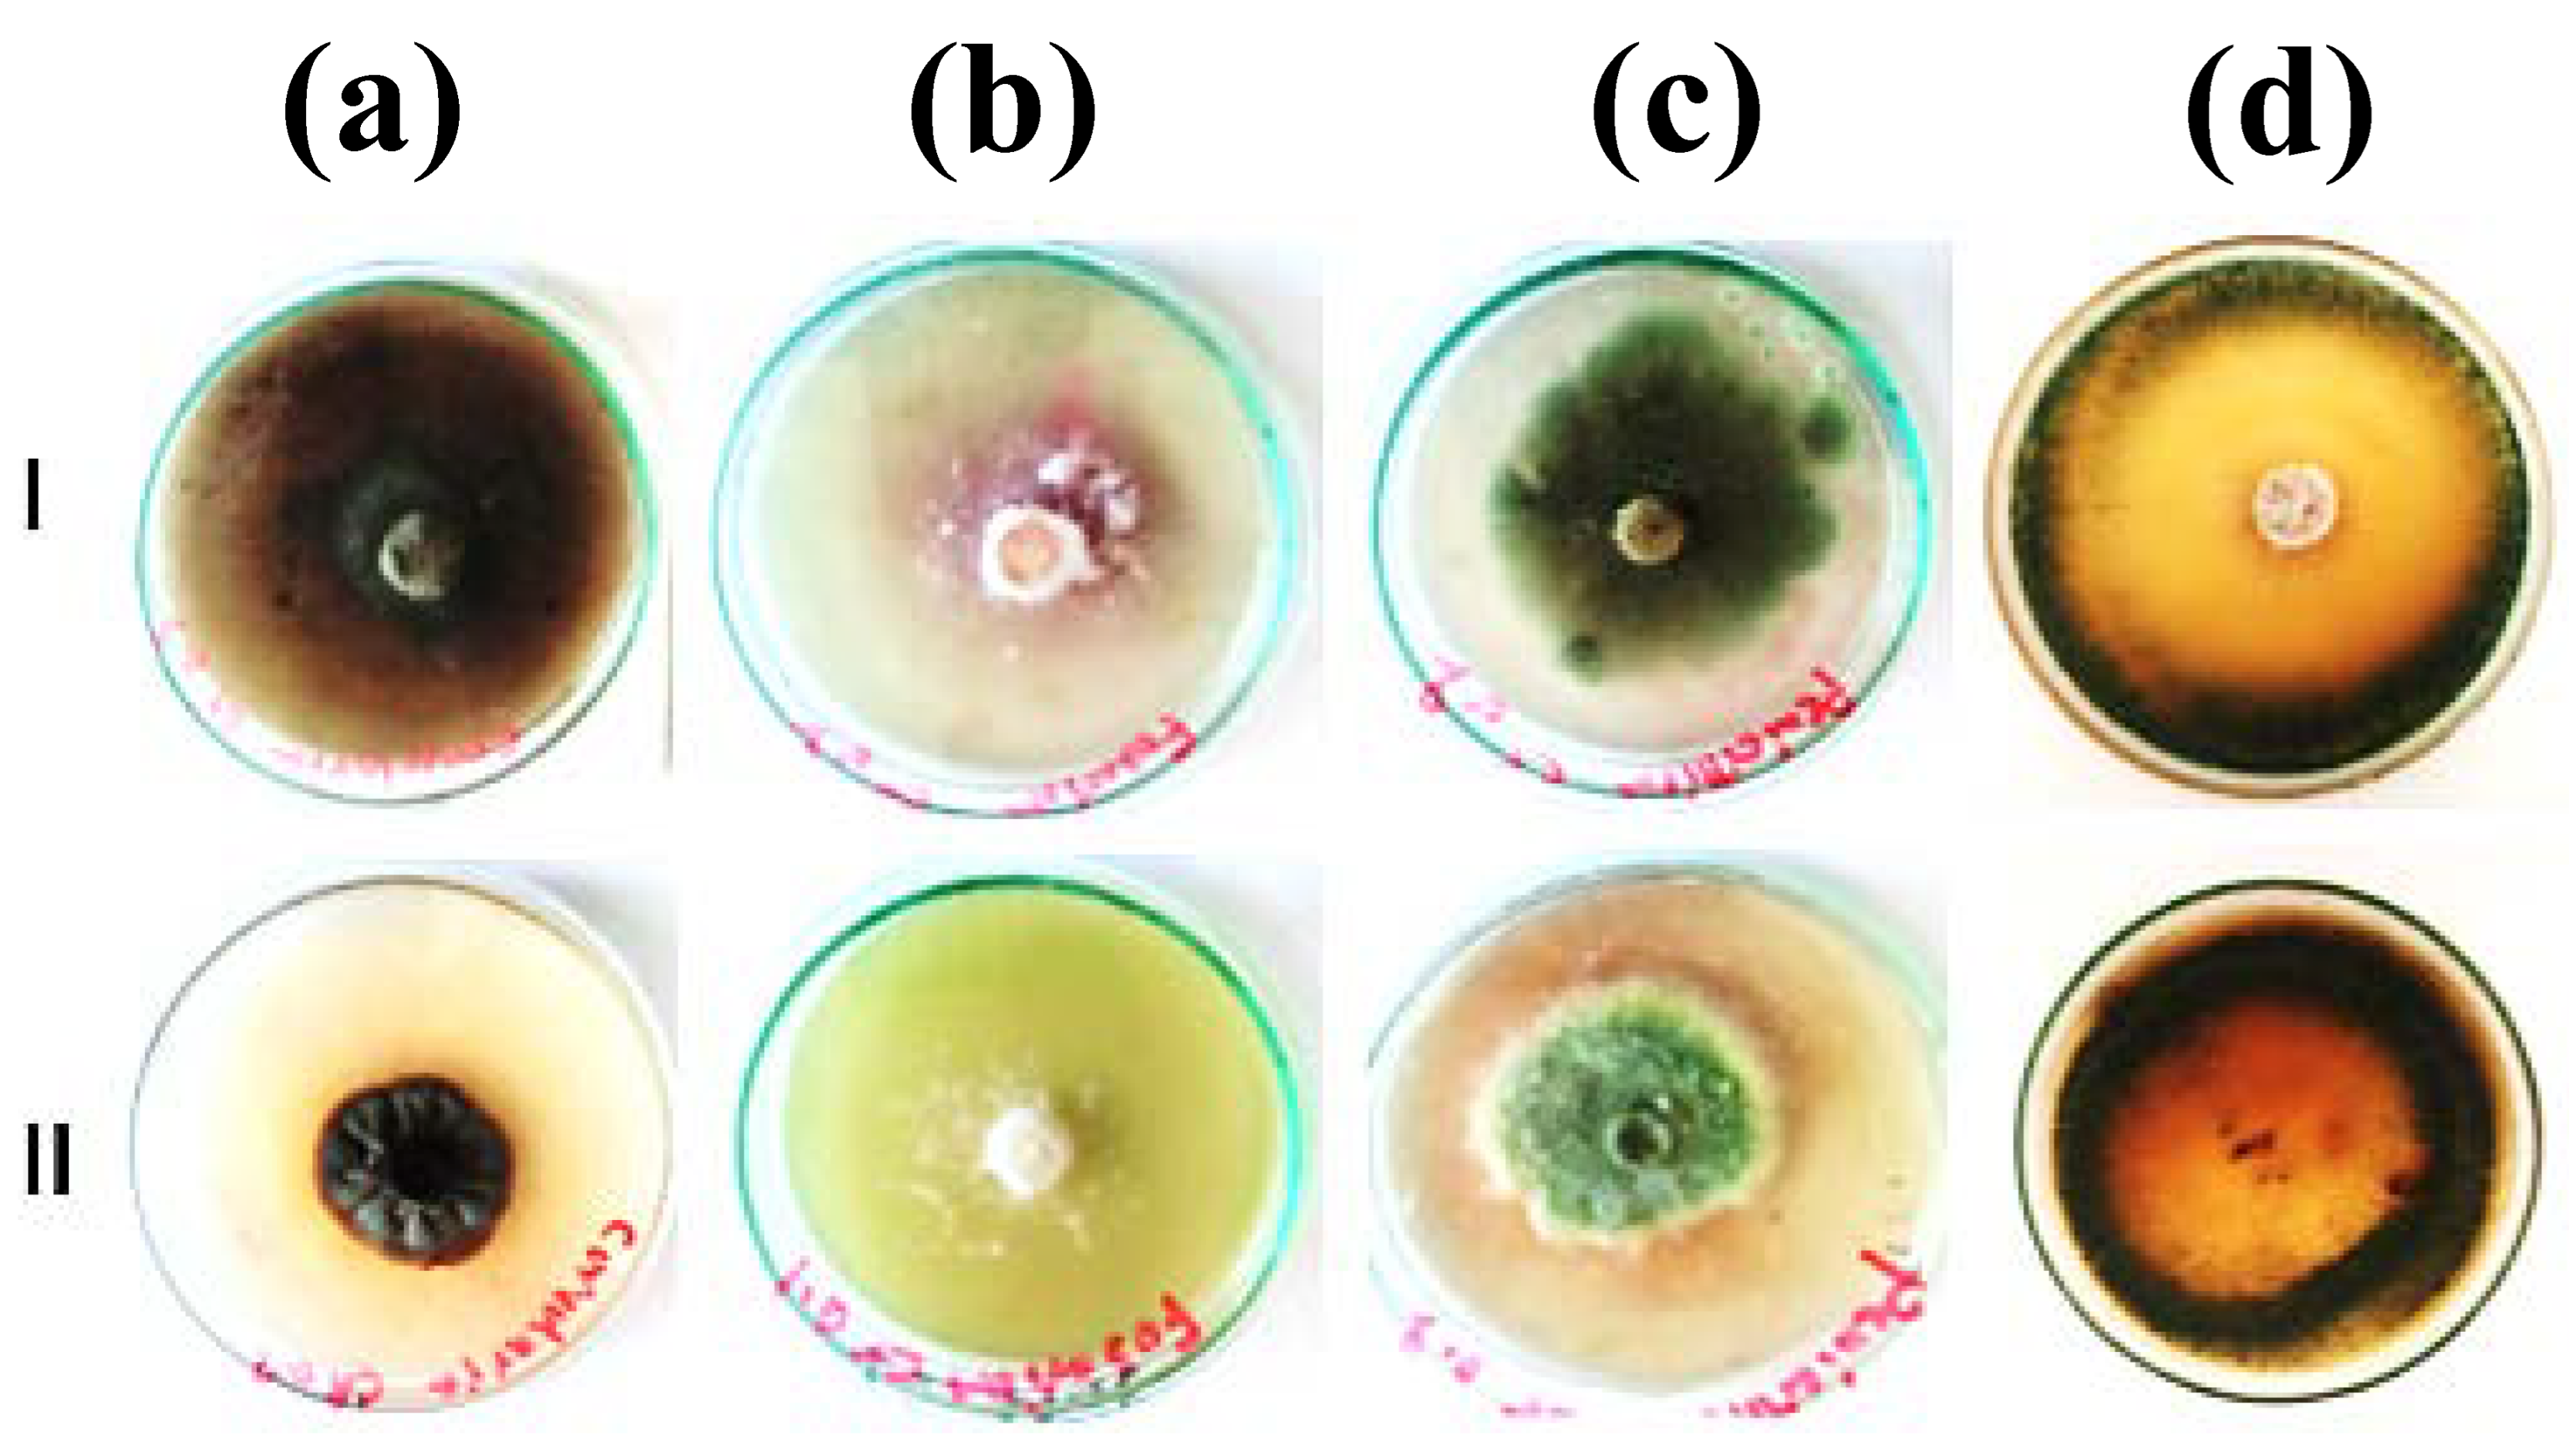
Jof 09 00382 g003

A Feasibility Study on the Recall of Metallophilic Fungi from Fe(III)-Contaminated Soil and Evaluating Their Mycoremediation Capacity: Experimental and Theoretical Study
Abstract
1. Introduction
2. Materials and Methods
2.1. Soil Collection and Characterization
2.1.1. Soil Collection and Preparation
2.1.2. Soil Characterization
2.2. Isolation and Characterization of Metallophilic Fungi
2.2.1. Metallophilic Fungi Isolation
2.2.2. Fungal Characterization
Macroscopic Characterization
Tolerance Index (TI)
Colony Morphology
Scanning Electron Microscopy (SEM)
Fourier-Transform Infrared Spectroscopy (FTIR)
2.3. Experimental Work of Adsorption
2.3.1. Adsorption Experiments
2.3.2. Adsorption Isotherms
2.4. Statistical Analysis
3. Results and Discussion
3.1. Soil Characterization
3.2. Isolation and Characterization of Metallophilic Fungi
3.2.1. Macroscopic Characterization
3.2.2. Tolerance Index (TI)
3.2.3. Colony Morphology
3.2.4. SEM Analysis
3.2.5. FTIR Analysis
3.3. Adsorption Studies
3.3.1. Effect of Initial Fe(III) Concentration
3.3.2. Effect of pH
3.3.3. Effect of Temperature
3.4. Adsorption Isotherm of Fe(III)
4. Conclusions
- (1)
- Four fungal species, including C.lunata, F. equiseti, P. pinophilum, and T. harzianum, were successfully isolated from contaminated soil.
- (2)
- The greatest Fe(III) tolerance was achieved for all fungal strains at 100 mg/L. Unlike P. pinophilum, the differences in Fe(III) tolerance of T. harzianum were limited at all Fe(III) concentrations, even at the highest values.
- (3)
- The morphological characterization by SEM found that there were efficient potential sites of biosorption on the mycelia surfaces responsible for Fe(III) bioaccumulation. Additionally, the Fe(III) bioaccumulation initiated changes in the morphological features of fungi, which can be observed in mycelial looping and twisting and small irregular folds.
- (4)
- Similarly, the Fe(III) removal (%) had the best performance of all experienced initial Fe(III) concentrations, including 50, 100, 150, and 200 mg/L for all studied samples. Meanwhile, the Fe(III) uptake (mg/g) gradually increased with the rising in the initial Fe(III) concentration from 50–200 mg/L to the highest at 200 mg/L.
- (5)
- For all addressed fungal strains, the pH values of 3 and 7 were found to be the optimum conditions with more superiority for the first value for Fe(III) removal (%) and uptake (mg/g). Regarding the temperature, the Fe(III) removal (%) and uptake (mg/g) had the best behavior at 28 and 20 °C, respectively. More specifically, at 28 °C, F. equiseti has the highest Fe(III) removal (89.5%), while the Fe(III) uptake (mg/g) decreases gradually from 20 to 37 °C, respectively, and was the highest at 20 °C. More specifically, T. harzianum has a maximum Fe(III) uptake of approximately 51.5 mg/g at 20 °C.
- (6)
- Unlike C. lunata, the highest values of Langmuir constants, qmax (72.46 mg/g) and KL (0.0260 L/mg), and Freundlich constants, KF (5.60 mg/g and n (2.20 L/mg), m were reported for T. harzianum, indicating the highest adsorption capacity and intensity, respectively.
Author Contributions
Funding
Institutional Review Board Statement
Informed Consent Statement
Data Availability Statement
Conflicts of Interest
References
- Mubarak, M.F.; Zayed, A.M.; Ahmed, H.A. Activated Carbon/Carborundum@Microcrystalline Cellulose core shell nano-composite: Synthesis, characterization and application for heavy metals adsorption from aqueous solutions. Ind. Crops Prod. 2022, 182, 114896. [Google Scholar] [CrossRef]
- Correia, A.A.; Matos, M.P.; Gomes, A.R.; Rasteiro, M.G. Immobilization of heavy metals in contaminated soils—Performance assessment in conditions similar to a real scenario. Appl. Sci. 2020, 10, 7950. [Google Scholar] [CrossRef]
- Ahmadpour, P.; Ahmadpour, F.; Mahmud, T.; Abdu, A.; Soleimani, M.; Tayefeh, F.H. Phytoremediation of heavy metals: A green technology. AJB 2012, 11, 14036–14043. [Google Scholar] [CrossRef]
- Rajkumar, M.; Ae, N.; Prasad, M.N.V.; Freitas, H. Potential of siderophore-producing bacteria for improving heavy metal phytoextraction. Trends Biotechnol. 2010, 28, 142–149. [Google Scholar] [CrossRef]
- Andrino, A.; Guggenberger, G.; Sauheitl, L.; Burkart, S.; Boy, J. Carbon investment into mobilization of mineral and organic phosphorus by arbuscular mycorrhiza. Biol. Fertil. Soils 2021, 57, 47–64. [Google Scholar] [CrossRef]
- Talukdar, S.; Singha, P.; Mahato, S.; Pal, S.; Liou, Y.-A.; Rahman, A. Land-use land-cover classification by machine learning classifiers for satellite observations—A review. Remote Sens. 2020, 12, 1135. [Google Scholar] [CrossRef]
- Filote, C.; Roșca, M.; Hlihor, R.M.; Cozma, P.; Simion, I.M.; Apostol, M.; Gavrilescu, M. Sustainable Application of Biosorption and Bioaccumulation of Persistent Pollutants in Wastewater Treatment: Current Practice. Processes 2021, 9, 1696. [Google Scholar] [CrossRef]
- Flouty, R.; Estephane, G. Bioaccumulation and biosorption of copper and lead by a unicellular algae Chlamydomonas reinhardtii in single and binary metal systems: A comparative study. J. Environ. Manag. 2012, 111, 106–114. [Google Scholar] [CrossRef]
- Hansda, A.; Kumar, V.; Anshumali. A comparative review towards potential of microbial cells for heavy metal removal with emphasis on biosorption and bioaccumulation. World J. Microbiol. Biotechnol. 2016, 32, 170. [Google Scholar] [CrossRef]
- Kulshreshtha, S.; Mathur, N.; Bhatnagar, P. Mushroom as a product and their role in mycoremediation. AMB Express 2014, 4, 1–7. [Google Scholar] [CrossRef]
- Yadav, M.; Singh, G.; Jadeja, R. Physical and chemical methods for heavy metal removal. Pollut. Water Manag. Resour. Strateg. Scarcity 2021, 245, 377–397. [Google Scholar] [CrossRef]
- Bünemann, E.K.; Smernik, R.J.; Doolette, A.L.; Marschner, P.; Stonor, R.; Wakelin, S.A.; McNeill, A.M. Forms of phosphorus in bacteria and fungi isolated from two Australian soils. Soil Biol. Biochem. 2008, 40, 1908–1915. [Google Scholar] [CrossRef]
- Ojuederie, O.B.; Babalola, O.O. Microbial and plant-assisted bioremediation of heavy metal polluted environments: A review. Int. J. Environ. Res. Public Health 2017, 14, 1504. [Google Scholar] [CrossRef]
- Olmstead, L.B.; Alexander, L.T.; Middleton, H.E. A Pipette Method of Mechanical Analysis of Soils Based on Improved Dispersion Procedure; U.S. Dept. of Agriculture: Washington, DC, USA, 1930. [Google Scholar]
- SU, S.L.; Singh, D.N.; Baghini, M.S. A critical review of soil moisture measurement. Measurement 2014, 54, 92–105. [Google Scholar] [CrossRef]
- Allen, S.; Grimshaw, H.; Parkinson, J.; Quarmby, C. Chemical Analysis of Ecological Materials; Blackwell Scientific Publications: Oxford, UK, 1989; p. 565. [Google Scholar]
- Soltanpour, P.; Schwab, A. A new soil test for simultaneous extraction of macro-and micro-nutrients in alkaline soils. Commun. Soil. Sci. Plant Anal. 1977, 8, 195–207. [Google Scholar] [CrossRef]
- Walkley, A.; Black, I.A. An examination of the Degtjareff method for determining soil organic matter, and a proposed modification of the chromic acid titration method. Soil. Sci. 1934, 37, 29–38. [Google Scholar] [CrossRef]
- Machuca, A.; Milagres, A. Use of CAS-agar plate modified to study the effect of different variables on the siderophore production by Aspergillus. Lett. Appl. Microbiol. 2003, 36, 177–181. [Google Scholar] [CrossRef]
- Oladipo, O.G.; Awotoye, O.O.; Olayinka, A.; Bezuidenhout, C.C.; Maboeta, M.S. Heavy metal tolerance traits of filamentous fungi isolated from gold and gemstone mining sites. Environ. Microbiol. 2018, 49, 29–37. [Google Scholar] [CrossRef]
- Ridgway, R. Color Standards and Color Nomenclature; The Author: Washington, DC, USA, 1912. [CrossRef]
- Heyman, H.M.; Senejoux, F.; Seibert, I.; Klimkait, T.; Maharaj, V.J.; Meyer, J.J.M. Identification of anti-HIV active dicaffeoylquinic-and tricaffeoylquinic acids in Helichrysum populifolium by NMR-based metabolomic guided fractionation. Fitoterapia 2015, 103, 155–164. [Google Scholar] [CrossRef]
- Foo, K.Y.; Hameed, B.H. Insights into the modeling of adsorption isotherm systems. J. Chem. Eng. 2010, 156, 2–10. [Google Scholar] [CrossRef]
- Zayed, A.M.; Selim, A.Q.; Mohamed, E.A.; Wahed, M.S.A.; Seliem, M.K.; Sillanpää, M. Adsorption characteristics of Na-A zeolites synthesized from Egyptian kaolinite for manganese in aqueous solutions: Response surface modeling and optimization. Appl. Clay Sci. 2017, 140, 17–24. [Google Scholar] [CrossRef]
- Langmuir, I. The constitution and fundamental properties of solids and liquids. Part I. Solids. J. Am. Chem. Soc. 1916, 38, 2221–2295. [Google Scholar] [CrossRef]
- Freundlich, H. Over the adsorption in solution. J. Phys. Chem. 1906, 57, 1100–1107. [Google Scholar]
- Joshi, N.; Kumar, A. Physico-chemical analysis of soil and industrial effluents of Sanganer region of Jaipur Rajasthan. Res. J. Agric. Sci. 2011, 2, 354–356. [Google Scholar]
- Mathur, N.; Kumar, A. Physico-chemical characterization of industrial effluents contaminated soil of Sanganer. J. Emerg. Trends Eng. Appl. 2013, 4, 226–228. [Google Scholar]
- Akbar, K.; Habib, K.; Mozhgan, S.; Mirhassan, R.S. Arbuscular mycorrhizal fungi and heavy metal contaminated soils. Afr. J. Microbiol. Res. 2011, 5, 1571–1576. [Google Scholar] [CrossRef]
- Yadav, A.N. Recent Trends in Mycological Research; Springer: Berlin/Heidelberg, Germany, 2021. [Google Scholar] [CrossRef]
- Oladipo, A.A. MIL-53 (Fe)-based photo-sensitive composite for degradation of organochlorinated herbicide and enhanced reduction of Cr (VI). PSEP 2018, 116, 413–423. [Google Scholar] [CrossRef]
- Zafar, S.; Aqil, F.; Ahmad, I. Metal tolerance and biosorption potential of filamentous fungi isolated from metal contaminated agricultural soil. Bioresour. Technol. 2007, 98, 2557–2561. [Google Scholar] [CrossRef]
- Boyce, K.J.; Andrianopoulos, A. Fungal dimorphism: The switch from hyphae to yeast is a specialized morphogenetic adaptation allowing colonization of a host. FEMS Microbiol. Rev. 2015, 39, 797–811. [Google Scholar] [CrossRef]
- Fogarty, R.V.; Tobin, J.M. Fungal melanins and their interactions with metals. Enzyme Microb. Technol. 1996, 19, 311–317. [Google Scholar] [CrossRef]
- Liaquat, F.; Haroon, U.; Munis, M.F.H.; Arif, S.; Khizar, M.; Ali, W.; Shengquan, C.; Qunlu, L. Efficient recovery of metal tolerant fungi from the soil of industrial area and determination of their biosorption capacity. Environ. Technol. Innov. 2021, 21, 101237. [Google Scholar] [CrossRef]
- Mishra, A.; Malik, A. Novel fungal consortium for bioremediation of metals and dyes from mixed waste stream. Bioresour. Technol. 2014, 171, 217–226. [Google Scholar] [CrossRef]
- Aytar, P.; Gedikli, S.; Buruk, Y.; Cabuk, A.; Burnak, N. Lead and nickel biosorption with a fungal biomass isolated from metal mine drainage: Box–Behnken experimental design. IJEST 2014, 11, 1631–1640. [Google Scholar] [CrossRef]
- Tripathi, R.; Gupta, R.K.; Singh, P.; Bhadwal, A.S.; Shrivastav, A.; Kumar, N.; Shrivastav, B. Ultra-sensitive detection of mercury (II) ions in water sample using gold nanoparticles synthesized by Trichoderma harzianum and their mechanistic approach. Sens. Actuators B Chem. 2014, 204, 637–646. [Google Scholar] [CrossRef]
- Tigini, V.; Prigione, V.; Donelli, I.; Anastasi, A.; Freddi, G.; Giansanti, P.; Mangiavillano, A.; Varese, G.C. Cunninghamella elegans biomass optimisation for textile wastewater biosorption treatment: An analytical and ecotoxicological approach. Appl. Microbiol. Biotechnol. 2011, 90, 343–352. [Google Scholar] [CrossRef] [PubMed]
- Qu, Q.; Li, S.; Li, L.; Zuo, L.; Ran, X.; Qu, Y.; Zhu, B. Adsorption and corrosion behaviour of Trichoderma harzianum for AZ31B magnesium alloy in artificial seawater. Corros. Sci. 2017, 118, 12–23. [Google Scholar] [CrossRef]
- Chen, S.H.; Cheow, Y.L.; Ng, S.L.; Ting, A.S.Y. Mechanisms for metal removal established via electron microscopy and spectroscopy: A case study on metal tolerant fungi Penicillium simplicissimum. J. Hazard. Mater. 2019, 362, 394–402. [Google Scholar] [CrossRef]
- Aryal, M.; Ziagova, M.; Liakopoulou-Kyriakides, M. Study on arsenic biosorption using Fe (III)-treated biomass of Staphylococcus xylosus. J. Chem. Eng. 2010, 162, 178–185. [Google Scholar] [CrossRef]
- Crini, G.; Badot, P.-M. Application of chitosan, a natural aminopolysaccharide, for dye removal from aqueous solutions by adsorption processes using batch studies: A review of recent literature. Prog. Polym. Sci. 2008, 33, 399–447. [Google Scholar] [CrossRef]
- Farhan, S.N.; Khadom, A.A. Biosorption of heavy metals from aqueous solutions by Saccharomyces Cerevisiae. Int. J. Ind. Chem. 2015, 6, 119–130. [Google Scholar] [CrossRef]
- Pawar, R.R.; Gupta, P.; Sawant, S.Y.; Shahmoradi, B.; Lee, S.-M. Porous synthetic hectorite clay-alginate composite beads for effective adsorption of methylene blue dye from aqueous solution. Int. J. Biol. Macromol. 2018, 114, 1315–1324. [Google Scholar] [CrossRef] [PubMed]
- Liaud, N.; Giniés, C.; Navarro, D.; Fabre, N.; Crapart, S.; Gimbert, I.H.; Levasseur, A.; Raouche, S.; Sigoillot, J.-C. Exploring fungal biodiversity: Organic acid production by 66 strains of filamentous fungi. Fungal Biol. Biotechnol. 2014, 1, 1–10. [Google Scholar] [CrossRef]
- Beveridge, T. The immobilization of soluble metals by bacterial walls. Proc. Biotechnol. Bioeng. Symp. 1986, 16, 127–139. [Google Scholar]
- Puig, S.; Lee, J.; Lau, M.; Thiele, D.J. Biochemical and genetic analyses of yeast and human high affinity copper transporters suggest a conserved mechanism for copper uptake. J. Biol. Chem. 2002, 277, 26021–26030. [Google Scholar] [CrossRef]

| Isotherm Model | Formula | Parameters | Refs. |
|---|---|---|---|
| Langmuir | Ce (mg/L): equilibrium concentration of the resting Fe(III) in the solution qe (mg/g): the removed amount of Fe(III) at equilibrium qmax (mg/g): maximum adsorption capacity kL (L/mg): Langmuir constant qmax = 1/slope | [25] | |
| Freundlich | Ce (mg/L): equilibrium concentration of the resting Fe(III) in the solution qe (mg/g): the removed amount of Fe(III) at equilibrium KF (mg/g): Fe(III) adsorption capacity. n: heterogeneity factor kF = 10intercept 1/n = slope | [26] |
| Soil Properties | Soil Sample |
|---|---|
| pH | 7.380 ± 0.008 |
| Electrical conductivity (mS/m) | 25.30 ± 0.50 |
| Organic carbon (%) | 0.330 ± 0.012 |
| Clay (%) | 12.50 ± 0.40 |
| Sand (%) | 43.33± 0.47 |
| Silt (%) | 44.16 ± 0.23 |
| Soil texture | Sandy loamy |
| Moisture content (%) | 2.00 |
| Available nutrients (mg/kg) | |
| N | 16.00 ± 0.20 |
| P | 8.00 ± 0.40 |
| K | 10.35 ± 0.05 |
| Heavy metal (mg/kg) | |
| Fe(III) | 118.40 ± 2.30 |
| Isolated Fungi | Colony Features on PDA Media 7-Day-Old |
|---|---|
| Curvularia lunata | Black colonies with brown-black reverse and fluffy texture |
| Fusarium equiseti | White-pinky colonies with white-pale yellow reverse and dense texture (lanose) |
| Penicillium pinophilum | Green colonies with yellow margins and pale orange-light orange reverse and velvety texture |
| Trichoderma harzianum | White mycelium with green colonies with yellowish reverse and cottony texture |
| Adsorbent | Initial Fe(III) Concentration (mg/L) | Isotherm Model | |||||
|---|---|---|---|---|---|---|---|
| Langmuir | Freundlich | ||||||
| Parameters | Parameters | ||||||
| qmax (mg/g) | KL (L/mg) | R2 | KF (mg/g) | N (L/mg) | R2 | ||
| Curvularia lunata | 50–200 | 61.34 | 0.0390 | 0.98 | 4.20 | 1.80 | 0.93 |
| Fusarium equiseti | 62.90 | 0.0380 | 0.97 | 4.50 | 1.88 | 0.94 | |
| Penicillium pinophilum | 63.30 | 0.0395 | 0.97 | 5.50 | 1.90 | 0.94 | |
| Trichoderma harzianum | 72.46 | 0.0260 | 0.94 | 5.60 | 2.20 | 0.95 | |
Disclaimer/Publisher’s Note: The statements, opinions and data contained in all publications are solely those of the individual author(s) and contributor(s) and not of MDPI and/or the editor(s). MDPI and/or the editor(s) disclaim responsibility for any injury to people or property resulting from any ideas, methods, instructions or products referred to in the content. |
© 2023 by the authors. Licensee MDPI, Basel, Switzerland. This article is an open access article distributed under the terms and conditions of the Creative Commons Attribution (CC BY) license (https://creativecommons.org/licenses/by/4.0/).
Share and Cite
Tagyan, A.I.; Yasser, M.M.; Mousa, A.M.; Alkhalifah, D.H.M.; Hozzein, W.N.; Marzouk, M.A. A Feasibility Study on the Recall of Metallophilic Fungi from Fe(III)-Contaminated Soil and Evaluating Their Mycoremediation Capacity: Experimental and Theoretical Study. J. Fungi 2023, 9, 382. https://doi.org/10.3390/jof9030382
Tagyan AI, Yasser MM, Mousa AM, Alkhalifah DHM, Hozzein WN, Marzouk MA. A Feasibility Study on the Recall of Metallophilic Fungi from Fe(III)-Contaminated Soil and Evaluating Their Mycoremediation Capacity: Experimental and Theoretical Study. Journal of Fungi. 2023; 9(3):382. https://doi.org/10.3390/jof9030382
Chicago/Turabian StyleTagyan, Aya I., Manal M. Yasser, Ahmed M. Mousa, Dalal Hussien M. Alkhalifah, Wael N. Hozzein, and Marym A. Marzouk. 2023. "A Feasibility Study on the Recall of Metallophilic Fungi from Fe(III)-Contaminated Soil and Evaluating Their Mycoremediation Capacity: Experimental and Theoretical Study" Journal of Fungi 9, no. 3: 382. https://doi.org/10.3390/jof9030382
APA StyleTagyan, A. I., Yasser, M. M., Mousa, A. M., Alkhalifah, D. H. M., Hozzein, W. N., & Marzouk, M. A. (2023). A Feasibility Study on the Recall of Metallophilic Fungi from Fe(III)-Contaminated Soil and Evaluating Their Mycoremediation Capacity: Experimental and Theoretical Study. Journal of Fungi, 9(3), 382. https://doi.org/10.3390/jof9030382

